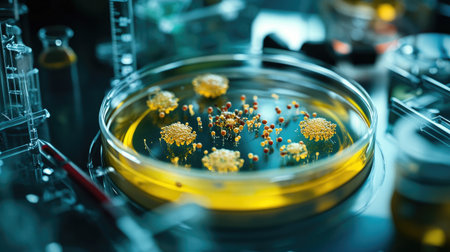
A vivid close-up view of a petri dish containing vibrant microbial growth, surrounded by various lab equipment, showcasing a dynamic scientific research environment.の素材

素材 - A vivid close-up view of a petri dish containing vibrant microbial growth, surrounded by various lab equipment, showcasing a dynamic scientific research environment.
作品情報
A vivid close-up view of a petri dish containing vibrant microbial growth, surrounded by various lab equipment, showcasing a dynamic scientific research environment.
- ID:260523664
- 作品種別:
- 作者名:Sampao wandee
キーワード
- academic research
- agar
- analysis
- analytics
- bacteria
- bioengineering
- biology
- biotechnology
- cellular biology
- chemicals
- culture
- culture medium
- discoveries
- education
- experiment
- exploration
- growth
- health
- health sciences
- innovation
- lab equipment
- lab work
- laboratory
- laboratory environment
- laboratory tools
- liquid
- microbial growth
- microorganisms
- microscope
- microscopic
- observation
- petri dish
- petri plate
- physics
- research
- researchers
- samples
- science
- science experiment
- seedlings
- small organisms
- sterile
- studies
- study
- surface
- testing
- yellow liquid
類似作品
Modern abstract...
A ball on a bui...
A single, perfe...
A stunning view...
A stunning view...
A futuristic si...
Engineer in har...
Smartphone fram...
Abstract view o...
A captivating v...
Close-up of a n...
A group of tall...
Colorful citysc...
A closeup shot ...
An aerial view ...
Apartment and o...
Explore a vibra...
Urban skyline m...
Old Courtyard I...
Captivating vie...
Camera lens wit...
Cluster of mode...
Bangkok city ni...
Beautiful bokeh...
Abstract liquid...
Frames made out...
A view through ...
Four tall rock ...
Aerial shot of ...
Condominium ret...
A tranquil scen...
Closeup of huma...
Aerial view of ...
LED VIP concept...
A captivating c...
building archit...
Tilting man in ...
Mountain landsc...
This striking c...
Sweden, Stockho...
A mesmerizing c...
airplane flyin ...
Crane
Stunning aerial...
Two red brick b...
3d illustration...
Majestic Nightt...
A hand holds a ...
A glimpse of Ko...